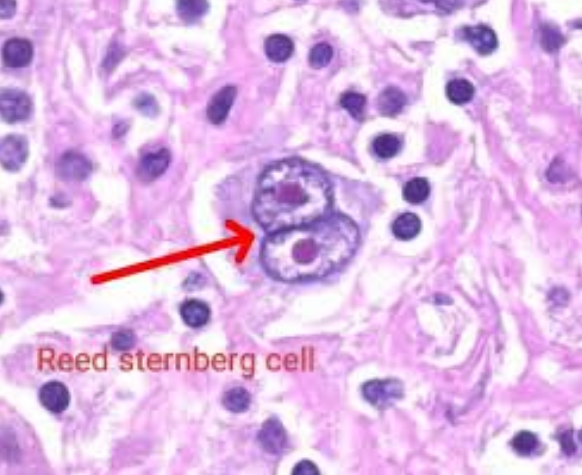
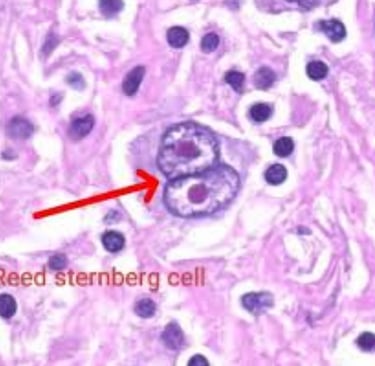

" Bilim. Kanıt. Şifa. | Dr. Aleksi: Yeni Nesil Sağlık Ekosistemi."
Lenfoma
KANSERLENFATİK SİSTEMTIBBIN MATEMATİĞİ & BAYES TEOREMİ
dr. Aleksi
4/24/202611 min oku


LENFOMALAR
Bağışıklık Şövalyelerinin Anarşiye Dönüşümü – Bayesyan Bir Mikroskobik Savaş Analizi
İnsan bedeni, her saniye trilyonlarca hücrenin kusursuz bir senfoni içinde dans ettiği devasa bir metropoldür. Bu metropolün en kritik savunma mekanizması, lenfatik sistemdir. Lenfositler (B, T ve NK hücreleri), dokular arasında devriye gezen, patojenleri tanıyan ve yok eden "bağışıklık şövalyeleri"dir. Ancak, bazen bu şövalyelerin genetik kodunda bir şeyler kırılır. Bir "dur" komutu, "devam et" komutuna dönüşür. İşte o an, şövalye anarşiste dönüşür ve kendi evine saldırmaya başlar. Bu, Lenfoma’nın doğuşudur.
Tıbbi teşhis, bu sessiz isyanı bastırmak için yapılan mikroskobik bir savaş taktiğidir. 1970'lerde Prof. F.T. de Dombal'ın Bayes teoremini karın ağrısına uygulamasıyla başlayan matematiksel devrim, bugün lenfomanın karmaşık dünyasında yönümüzü bulmamızı sağlayan en keskin fenerimizdir. Bu yazıda, lenfoma teşhisini bir eczane mantığından çıkarıp, ihtimallerin matematiği (Bayes) ve sistem biyokimyası (Fonksiyonel Tıp) ile harmanlanmış bir "frekans mühendisliği" disiplini gibi inceleyeceğiz.
BÖLÜM 1: Düşmanın Anatomisi ve Epidemiyolojik Ön-Test Olasılığı (Prior)
Bayesyan analizde ilk adım, hiçbir test yapmadan önce hastanın kim olduğuna bakarak bir "başlangıç olasılığı" (Prior) belirlemektir.
Lenfomalar, Dünya Sağlık Örgütü'nün (WHO) 2022 yılında yayınlanan 5. baskısına göre, moleküler karakterlerine göre yüzlerce alt tipe ayrılan devasa bir spektrumdur. Ancak pratik klinikte iki ana başlıkta toplanır:
1. Hodgkin Lenfoma (HL)
Tüm lenfomaların yaklaşık %10-15’ini oluşturur. Mikroskop altında bakıldığında, "Baykuş Gözü" görünümündeki devasa Reed-Sternberg (RS) hücreleri ile tanınır. Bu hücreler cüretkardır ama azınlıktadır; tümör kitlesinin sadece %1-2’sini oluşturur, geri kalanı inflamatuar hücrelerdir.
Bayesyan Veri (Yaş): Yaş dağılımı bimodaldir. İlk pik genç erişkinlerde (15-30 yaş), ikinci pik ise >55 yaşta görülür. Genç bir hastada izole boyun kitlesi, HL için ön olasılığı (prior) %10'lardan %40'lara fırlatır.
2. Non-Hodgkin Lenfoma (NHL)
Devasa, heterojen ve çok daha agresif bir gruptur (%85-90). Reed-Sternberg hücreleri yoktur. B-hücresi (%85-90) veya T-hücresi/NK-hücresi (%10-15) kaynaklı olabilirler.
Epidemiyolojik Bayes:[1] Yaşla birlikte risk artar (Medyan yaş 67). 65 yaşında, yaygın lenfadenopati (LAP) ve B semptomları olan bir hastada NHL ihtimali (LR+), HL’den katbekat yüksektir.
Alt Tip Farkındalığı:[2]
Agresif (Yüksek Dereceli): Diffüz Büyük B-Hücreli Lenfoma (DLBCL) - En sık görülen NHL tipidir.
İndolent (Düşük Dereceli): Foliküler Lenfoma (FL) - Yavaş seyreder ama genelde kür zordur.
BÖLÜM 2: Bedenin Fısıltılarını Matematiksel Olarak Tartmak: Olabilirlik Oranları (LR)
Hasta polikliniğe girdiğinde, Bayesyen algoritmamız "Olabilirlik Oranları" (Likelihood Ratio - LR) ile tanısal güncellemeleri başlatır. (Not: LR+ >10 ise test "teşhis koydurucuya yakın", LR- <0.1 ise test "ekarte ettirici"dir).
Semptomların Akustiği ve "Kırmızı Bayraklar"
Lenfoma genellikle sessiz, ağrısız büyüyen bir lenf bezi (Lenfadenopati - LAP) ile başlar. Reaktif bir LAP soft ve ağrılıdır; lenfoma ise farklı bir akustik rezonans verir: Ağrısız, Lastik Kıvamında (Rubbery), Birbirine Yapışık (Matting) ve >2 cm.
B Semptomları: Tümör Metabolizmasının Çığlığı
Açıklanamayan Ateş (>38°C), Gece Terlemeleri (çamaşır değiştirecek kadar), Son 6 ayda %10'dan fazla Kilo Kaybı.
Bayesyan Analiz:[3]
Sensitivite: ~%30-40 (Erken evre HL’de çok düşüktür).
Spesifite: ~%85-90.
LR+: ~3.5 - 4.0. (B semptomları varsa, lenfoma/kanser ihtimali 4 kat artar).
LR-: ~0.7. (B semptomlarının olmaması, lenfomayı ekarte ettirmez! Özellikle indolent NHL’de B semptomu nadirdir.)
Fizik Muayene ve Kritik Bölgeler
Supraklaviküler (Köprücük kemiği üstü) bölgedeki bir LAP, Bayesyan alarm zillerinin en yüksek perdeden çaldığı andır. Bu bölgedeki bir LAP'ın malign olma LR+ değeri > 10'dur.
Önemli muayene noktaları
Lenf nodu muayenesi: boyun, supraklaviküler, aksilla, epitroklear, inguinal; boyut, kıvam, hareketsizlik, ağrı, hızlı büyüme.
Mediastinal muayene: venöz dolgunluk, SVC sendromu bulguları, stridor/nefes darlığı.
Karın muayenesi: hepatomegali, splenomegali, kitle.
Cilt: eritemli nodüller (bazı T-hücreli NHL’lerde), pruritus.
Nörolojik: spinal kord basısı bulguları (acil).
Fizik muayenenin katkısı (tahmini LLR)
Bulgular Sens Spes LR+ LR− Not
Supraklaviküler LAP: Sens. ~15–30% Spes. ~90–95% LR+ ~2–6 LR- ~0.7–0.9 Yüksek riskli bölge
Lenf nodu boyutu >2–3 cm. Sens.~25–45% Spes. ~70–85% LR+ ~1.5–3 LR- ~0.7–0.9 Boyut tek başına yetersiz
Hızlı büyüyen LAP: Sens. ~10–25% Spes. ~85–95% LR+ ~2–5 LR- ~0.8–0.95 Red flag
Splenomegali (palpe edilebilir): Sens. ~15–35% Spes. ~80–90% LR+ ~1.5–4 LR- ~0.7–0.95 NHL/HL’de değişken
Bayesçi yorum: Supraklaviküler LAP, düşük sensitiviteye rağmen LR+’yı artırabilir; görüntüleme ve biyopsi gereksinimini yükseltir.
Laboratuvar testleri
Sıklıkla kullanılanlar ve katkıları (tahmini değerler)
Test Sens Spes LR+ LR− Not
CBC: anemi: Sens. ~30–50% Spes. ~60–75% LR+ ~1–2 LR- ~0.7–0.9 Nonspesifik
CBC: lökopeni/lökositoz: Sens. ~20–40% Spes. ~70–85% LR+ ~1–2.5 LR- ~0.7–0.95 Evre/alt tip ilişkili
Trombositopeni: Sens. ~15–35% Spes. ~80–90% LR+ ~1–3.5 LR- ~0.7–0.95 Kemik iliği tutulumunda daha sık
LDH yüksekliği: Sens. ~40–60% Spes. ~60–75% LR+ ~1.5–2.5 LR- ~0.5–0.8 Tümör yüküyle ilişkili; agresif NHL’de daha belirgin
β2-mikroglobulin yüksekliği: Sens. ~45–70% Spes. ~55–70% LR+ ~1.5–2.5 LR- ~0.4–0.8 FL, DLBCL, CLL’de faydalı (prognostik)
ESR/CRP yüksekliği: Sens. ~40–70% Spes. ~50–70% LR+ ~1–2.5 LR- ~0.4–0.8 B semptomlarıyla korele; spesifik değil
Serum immünoglobulinler (hipogamaglobulinemi): Sens. ~15–40% Spes. ~75–90% LR+~1–4 LR- ~0.7–0.95 NHL’de özellikle B-hücreli hastalıklarda
Hepatit/HIV serolojileri: Sens. Değişken Spes. Yüksek LR+ Yüksek LR- DüşükTedavi planlaması ve risk için kritik
Bayesçi yorum: Laboratuvar testleri tek başına tanı koydurmaz; ancak prior’ı modüle eder ve görüntüleme/biyopsi kararını destekler. LDH/β2M gibi belirteçler, risk sınıflaması (IPI/FLIPI/IPS) için daha değerlidir.
Acil / yüksek risk bulgular (hemen değerlendirme gerektirir)
SVC sendromu (boyun/kol ödemi, yüz kızarıklığı, dispne)
Spinal kord basısı (alt ekstremite güçsüzlük, sfinkter bozukluğu)
Hızlı büyüyen kitle + hava yolu obstrüksiyonu
Şiddetli kanama/ileri sitopeniler (Kan hücrelerindeki düşük değerler)
Bakteriyemi/şok ile seyreden febril nötropeni (tedavi sırasında)
Akut böbrek yetmezliği (ürat obstrüksiyonu, TLS riski)
Bayesçi yorum: Bu durumlarda prior (çn tahmin olasılığı) çok yüksektir; görüntüleme + biyopsi acil planlanır, tedavi gecikmemelidir.
BÖLÜM 3: Laboratuvar ve Görüntülemenin Kodlarını Çözmek
Klinik şüphe prior olasılığımızı %40'lara taşıdı. Şimdi bu olasılığı kesinleştirecek testlere ihtiyacımız var.
1. Kanın Laboratuvar Sorgusu
LDH (Laktat Dehidrogenaz): Hücre yıkımının, tümör yükünün ve tümörün "elektriksel entropisinin" (bozulma hızı) göstergesidir.
Bayes: Sensitivite %60, Spesifite %70. LR+ ~2.0. Tek başına tanı koydurmaz ama Agresif NHL’de prior olasılığı artırır ve prognozu belirler.
Beta-2 Mikroglobulin: Özellikle NHL’de (FL, CLL/SLL) tümör yükü ve prognoz için kritik bir LR modülatörüdür.
2. Görüntüleme Devrimi: PET-CT (Altın Standart)
Görüntüleme yöntemleri (USG, BT, PET/BT, MR)
Amacı
Lenfadenopati lokalizasyonu ve boyut
Evreleme (lenf nodları + ekstranodal tutulum + kemik iliği)
Tedavi yanıtı değerlendirmesi
Biyopsi planlaması (en uygun nod seçimi)
Test performansları (tahmini; protokole ve popülasyona göre değişir)
Yöntem Sens Spes LR+ LR− Not
USG (lenf nodu morfolojisi) Sens. ~70–85% Spes. ~60–75% LR+ ~2–3.5 LR- ~0.2–0.5
Biyopsi hedefi seçmede faydalı; kesin tanı değil
BT (evreleme) Sens. ~75–90% Spes. ~70–85% LR+ ~3–6 LR- ~0.1–0.3
Boyut kriterleri; inflamasyonla örtüşme
PET/BT (evreleme): Sens.~85–95% Spes. ~80–90% LR+ ~5–10 LR- ~0.05–0.2
Yanıt değerlendirmesi ve upstaging/downstaging için güçlü
MR (spinal kord, beyin, yumuşak doku): Sens. ~80–95% Spes. ~75–90% LR+ ~4–10 LR- ~0.05–0.25
Spinal kord basısı, ekstranodal tutulumda tercihli
Kemik sintigrafisi: Sens. ~60–75% Spes. ~70–80% LR+ ~2–4 LR- ~0.3–0.6
PET/BT’ye göre tanısal değeri daha düşük; halen bazı merkezlerde kullanılır
Bayesçi yorum:
PET/BT, evreleme ve tedavi yanıtında LR+’yı önemli ölçüde artırır (özellikle HL ve bazı NHL’lerde).
Ancak PET pozitifliği inflamasyonla karışabilir → biyopsi gereksinimi devam eder.
Sınırlılıklar: PET/BT performansı alt tipe bağlıdır; düşük FDG tutulumu olan indolent NHL’lerde duyarlılık düşebilir.
Metabolik olarak aktif tümör dokusunun (florodeoksiglikoz - FDG tutulumu) şeker tüketimini gösteren PET-CT, teşhis algoritmamızın keskin nişancısıdır.
Bayesyan Veri:[4]
Sensitivite: %95-98 (Mükemmel ekarte edici).
Spesifite: %90.
LR+ : ~9.5 (Pozitif bir PET, lenfoma ihtimalini dramatik şekilde artırır).
LR- : ~0.05 (FDG tutulumu yoksa, agresif lenfoma ihtimalini neredeyse sıfıra indiririz).
Kritik Kriter: Deauville Skoru (5 Nokta Skoru):[5] PET tutulumunu mediasten ve karaciğer tutulumu ile karşılaştıran standart bir dildir.
Deauville 1-3: Negatif (Tedaviye yanıt veya reaktif tutulum).
Deauville 4-5: Pozitif (Aktif tümör veya progresyon).
BÖLÜM 4: Kesin Hüküm: Dokunun Histopatolojik ve Genetik Şifresi
Tanı algoritması ve kriterler (WHO sınıflaması, Lugano/PET kriterleri, DDx)
. Klinik algoritma (önerilen akış)
Şüpheli LAP / B semptomları / red flag
Ön olasılık tahmini (yaş, risk faktörleri, semptomlar, fizik muayene)
Laboratuvar (CBC, LDH, β2M, ESR/CRP, serolojiler)
Görüntüleme (USG → BT/PET-BT; lokalizasyon ve evreleme)
Eksizyonel/insizyonel biyopsi (en uygun nod)
Patoloji + IHC + moleküler → WHO alt tipi
Evreleme (Lugano sınıflaması) + risk skorları (IPI/FLIPI/IPS vb.)
Tedavi planı + yanıt değerlendirmesi (PET/BT)
. Ayırıcı tanı (DDx) ve LLR (tahmini)
DDx Sens Spes LR+ LR− Not
Reaktif lenfadenopati (enfeksiyon, otoimmün) Sens. Yüksek Spes. Düşük LR+ ~0.5–2 LR- ~0.5–0.9
En sık benign neden
KLL/SLL (indolent NHL): Sens. Değişken Spes. Orta LR+ ~2–5 LR- ~0.5–0.8
Periferik lenfositoz, immünfenotip
Granülomatöz hastalık (tüberküloz, sarkoidoz): Sens. Orta Spes. Orta LR+ ~2–4 LR- ~0.5–0.8
Klinik, kültür, histoloji
Metastatik kanser (baş-boyun, meme, akciğer vb.): Sens. Orta Spes. Orta LR+ ~2–5 LR- ~0.5–0.8
Primer odağı arayın
Bayesçi çıkarım: DDx sıralaması, ön olasılığı ve biyopsi hedefini belirler. “En olası benign (iyi huylu bir hastalık)” bile olsa, persistan/red flag’li LAP’ta biyopsi düşünülmelidir.
Klinik bilgilerin bayesyan değerleri yol gösterir, ancak kanıta dayalı tıpta nihai mühür patoloğundur.
1. Biyopsi Protokolü: İiAB’den Kaçınmak
İnce İğne Aspirasyon Biyopsisi (İİAB), lenfoma şüphesinde LR- değeri çok kötü (~0.4) olduğu için algoritma dışıdır. İğne temiz gelse bile lenfoma olmadığını kanıtlamaz.
Teşhisin Altın Standardı:[6] Eksizyonel Lenf Nodu Biyopsisi (Düğümün Tamamının Çıkarılması). Doku mimarisi korunmalıdır. Sensitivite/Spesifite %100’e yaklaşır.
2. Patoloji Raporunun Derinlikleri (Immünohistokimya - IHC)
Patolog, hücrelerin yüzeyindeki "antenleri" (Antijenleri) boyayarak anarşistin kimliğini belirler.
Hodgkin Lenfoma: RS hücreleri CD15+ ve CD30+, ancak genellikle B-hücre anteni olan CD20-’dir.
Non-Hodgkin Lenfoma (B-hücreli): Genellikle CD20+’dir.
Kritik Belirteç: Ki-67 (Proliferasyon İndeksi). Hücrelerin ne kadar hızlı bölündüğünü gösterir. Burkitt Lenfoma’da %100’e yaklaşır (Çok agresif!).
3. Moleküler Hack: FISH ve PCR
Genetik kırılmaları tespit eder.
Örnek: DLBCL'de MYC, BCL2 ve BCL6 genlerinin translokasyonu (Double-hit veya Triple-hit lenfoma), çok agresif seyir gösteren spesifik bir genetik imza (Signature)'dır.
BÖLÜM 5: Battlefield’ı Haritalamak: Evreleme ve Lugano Kriterleri
Tanıyı koyduk, şimdi tümörün bedenin hangi metropollerinde yayıldığını haritalamalıyız. Lugano sınıflaması (2014) PET-CT temellidir.[7]
Evre Kriterler
Evre I Tek bir lenf nodu bölgesi veya tek bir lenfoid organ tutulumu.
Evre II Diyaframın aynı tarafında, iki veya daha fazla lenf nodu bölgesi tutulumu.
Evre III Diyaframın her iki tarafında lenf nodu tutulumu.
Evre IV Ekstranodal (lenf sistemi dışı) organların (kemik iliği, karaciğer, akciğer) yaygın tutulumu.
Kritik Güncelleme (Kemik İliği Biyopsisi):[8] Hodgkin Lenfoma ve Agresif NHL’de PET-CT negatif ise kemik iliği tutulumunu ekarte etmek için kemik iliği biyopsisi gereksinimi WHO 2022 ile azalmıştır; PET-CT bu konuda çok daha duyarlıdır. Ancak indolent NHL’de hala zorunludur.
BÖLÜM 6: Karşı Taarruz: Klasik Tedavi Protokolleri ve Prognoz
Modern tıp, lenfomayı tedavi edilebilir bir hastalığa dönüştürmüştür.
Hodgkin Lenfoma: Erken evrelerde ABVD kemoterapi protokolü ile kür oranı %85-90’ın üzerindedir.
Non-Hodgkin Lenfoma (B-hücreli): Anti-CD20 monoklonal antikoru Rituximab’ı içeren R-CHOP protokolü devrim yaratmıştır.
Geleceğin Standartları: CAR-T Hücre Tedavisi (Hastanın kendi T hücrelerinin genetik olarak lenfomayı tanıyacak şekilde hacklenmesi).
BÖLÜM 7: Fonksiyonel Onkoloji ve Biyokimyasal Destek: Mikroçevreyi Hacklemek
Bir EBM hekimi / insan mühendisi olarak tümörü yok ederken, tümörün oluşmasına izin veren Tümör Mikroçevresini (Tumor Microenvironment) de onarmalıyız. Fonksiyonel onkoloji, ana tedaviyi destekleyen, kemoterapinin etkinliğini artıran (Sinerjistik) ve toksisiteyi azaltan kanıta dayalı fitokimyasalları sürece dahil eder.
GPR133 (ADGRD1) ve Yeni Hedefleme Visyonu
Yeni araştırmalar, kemik metabolizmasında GPR133 reseptörünün mekanosensitif rolünü aydınlatmıştır. Fonksiyonel tıp, kemoterapi sırasında kemik ve kas yapısını korumak için bu yolağı (Wnt/β-katenin) doğal metabolitlerle modüle eder.
Sinerjistik Bitkisel Metabolitler ve Biyo-yararlanım Sorunu
Bu ajanlar tek başına bir "kür" değil, onkoloji protokolüne entegre modülatörlerdir.
Bitkisel Bileşen / Metabolit Moleküler Mekanizma Kritik Fonksiyonel Detay
Kurkumin (Curcumin) - Curcuma longa: Lenfoma patogenezinde kritik NF-kB ve STAT3 inflamatuar sinyal yolaklarını inhibe eder. İlaç direncini kırmaya yardımcı olabilir. Biyo-yararlanım Sorunu: Klasik kurkumin bağırsaktan emilmez. Lipozomal veya karabiber-piperin ile kombine formlar şarttır.
EGCG - Camellia sinensis (Yeşil Çay ekstraktından bir metaboliit): Klinik öncesi çalışmalarda apoptozu (programlı hücre ölümü) indüklediği ve anjiyogenezi baskıladığı gösterilmiştir. İndolent NHL’de hücre döngüsünü durdurabilir. Yüksek dozlarda karaciğer toksisitesi riski; onkoloji kontrolünde kullanılmalıdır.
Resveratrol - Vitis vinifera (Üzüm çekirdeği): Antioksidan ötesinde, lenfoma hücrelerinde PI3K/AKT/mTOR yolağını modüle ederek proliferasyonu yavaşlatır. İlaç metabolizması ile etkileşime girebilir (Sitokrom P450 inhibisyonu).
Kritik Fonksiyonel Uyarı: Tıbbi Mantarlar (Beta-glukanlar)
Reishi, Turkey Tail gibi mantarlar bağışıklık modülasyonu yapsa da, lenfoma zaten bir bağışıklık hücresi kanseridir. Bağışıklık sistemini kontrolsüzce "stimüle etmek" anarşist lenfositlerin daha da çoğalmasına yol açabilir. Bitkisel destekler mutlaka Bayesyan fayda-zarar analizi yapılarak onko-hematoloji ekibiyle entegre kullanılmalıdır.[9]
SON SÖZ: Geleceğin Entegre Tıbbı
Lenfoma, karmaşık bir sessiz isyandır. Teşhis ve tedavi süreci, olasılıkların matematiği, görüntüleme teknolojisi, mikroskobik patoloji ve hücre içi biyokimyanın kusursuz bir senfonisidir. Dr. de Dombal'ın yaktığı Bayes meşalesi ve fonksiyonel tıbbın kök nedenlere odaklanan merceği, Computer Asisted Programların tanı sistemleriyle birleştiğinde; sadece teşhiste değil, iyileşme sürecinde de mucizeler yaratma potansiyeli sunmaktadır. Biz hekimler, bu elektriksel ve biyokimyasal mimariyi "hack" etmeyi öğrenerek, hastalarımızı sadece hayatta tutmayı değil, onları gençlik çağındaki dinamik tolerans seviyesine geri döndürmeyi hedeflemeliyiz.
Kaynakça
[1] National Comprehensive Cancer Network (NCCN) Guidelines — B-Cell Lymphomas / Hodgkin Lymphoma (Güncel Sürüm).
[2] Swerdlow SH, et al. WHO Classification of Tumours of Haematopoietic and Lymphoid Tissues. 5th Ed. (2022).
[3] Deeks JJ, et al. Cochrane Handbook for Systematic Reviews of Diagnostic Test Accuracy (LR metodolojisi).
[4] Barrington SF, et al. consensus recommendations for initial evaluation, staging, and response assessment of Hodgkin and Non-Hodgkin Lymphoma. JCO. (2014). PMID: 24982401.
[5] Cheson BD, et al. recommendations for initial evaluation, staging, and response assessment of Hodgkin and Non-Hodgkin Lymphoma: the Lugano classification. JCO. (2014). PMID: 24982406.
[6] Swerdlow SH, et al. ibid.
[7] Cheson BD, et al. ibid.
[8] National Comprehensive Cancer Network (NCCN) Guidelines.
[9] Memorial Sloan Kettering Cancer Center — About Herbs (Güncel monograflar).